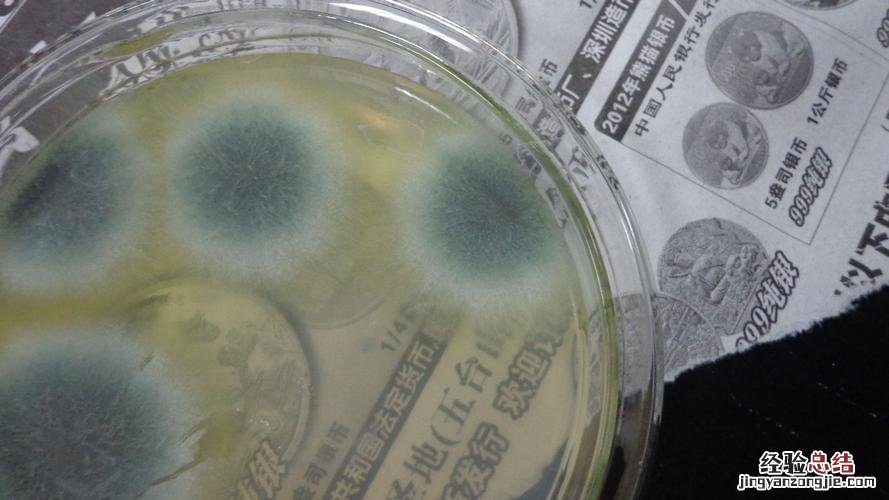

【孢子生殖是什么】
【孢子生殖是什么】孢子生殖是一种通过孢子直接发育成新个体的繁殖方式 。这种方式广泛应用于很多孢子植物和真菌等生物中 。孢子是一种特殊的生殖细胞,具有繁殖和休眠的功能 。真菌、植物、藻类和原生动物等可以产生孢子,这些孢子包括分生孢子、孢囊孢子和游动孢子等类型 。其中,植物通过无性生殖形成的孢子被称为“无性孢子”,而通过有性生殖形成的孢子被称为“有性孢子”,如接合孢子、卵孢子、子囊孢子和担孢子等 。
经验总结扩展阅读
-
蜗牛去眼袋用什么牌子的眼霜效果好 6款真正有效的去眼袋眼霜排名
-
-
景甜凭什么景甜就是“合照杀手”?因为第一眼美女都有0感底妆
-
-
-
-
-
-
-
-
-
|离异女友拿走18万礼金后消失,还矢口否认?福建大龄痴情男子坚持不报警
-
-
诺基亚EOS 1020支持扩展储存卡吗?支持多大的储存卡?
-
-
-
热播剧《我的前半生》中把罗子君的“中年危机”暴露在了大众的面前 人到中年,你要学会“富养”自己
-
-
-
2022年10月6日是做法事吉日吗 2022年10月6日做法事行吗